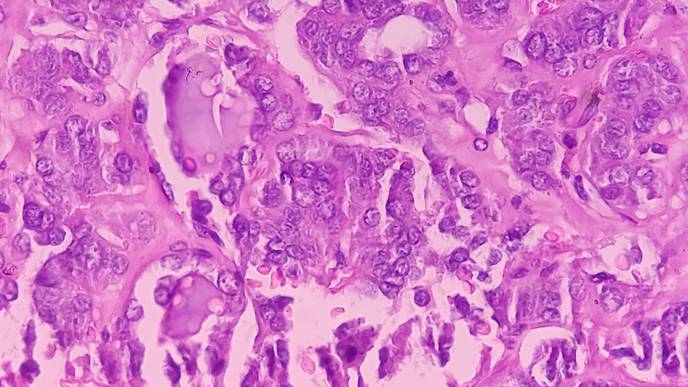
ReachMD Healthcare Image

Researchers Identify Key Characteristics Associated with Improved CAR T Outcomes in Large B Cell Lymphoma
TAMPA, Fla. — Chimeric antigen receptor T-cell therapy, or CAR T, has dramatically improved the treatment of certain blood cancers. Initially approved for patients who had failed multiple lines of therapy, clinical trials have shown CAR T can be used as an earlier treatment option. One such trial, ZUMA-7, compared axicabtagene ciloleucel (axi-cel) with standard-of-care therapy, which includes high-dose chemotherapy followed by an autologous stem cell transplant, for patients with recurrent or treatment-resistant large B-cell lymphoma. The trial resulted in the U.S. Food and Drug Administration approving axi-cel as second line therapy for this patient population. Still, researchers wanted to assess if there were specific tumor characteristics associated with improved outcomes that could better inform treatment selection. Their findings were published today in Nature Medicine.
Axi-cel CAR T targets the CD19 molecule on large B-cell lymphoma cells. The ZUMA-7 trial demonstrated that axi-cel reduced the risk of disease progression, the need for new therapy, or death by 60% compared to standard therapy. Despite these positive outcomes in event-free survival and overall survival, some patients did not respond well to therapy or relapsed quickly after treatment.
A team of researchers led by Dr. Frederick L. Locke, chair of the Blood and Marrow Transplant and Cellular Immunotherapy Department at Moffitt Cancer Center, analyzed tumor gene expression patterns from patient samples and determined that a B-cell gene expression signature and CD19 protein expression were significantly associated with improved event-free survival for patients treated with axi-cel but not standard therapy. Patients with lower tumor cell levels of CD19 had gene expression patterns associated with immune suppression. These observations suggest that the tumor immune environment may play an important role in regulating axi-cel therapy and outcomes. In addition, biomarkers associated with improved outcomes to axi-cel therapy decreased as patients had more treatments, suggesting that receipt of axi-cel in earlier lines of treatment is essential to ensure better patient outcomes.
Within the standard therapy group, the researchers discovered that patients who had a high tumor burden or elevated levels of the enzyme lactate dehydrogenase had shorter event-free survival. Additionally, patients with a nongerminal center B cell-like molecular subtype of large B-cell lymphoma had poorer outcomes with standard therapy. In contrast, molecular subtypes were not associated with axi-cel outcomes, suggesting axi-cel may overcome some mechanisms of resistance to standard therapy.
“Knowledge of the immune contexture is essential for understanding mechanisms of action and likelihood of prolonged response to CAR T-cell therapy. Collectively, these data may help inform studies evaluating patient management based on tumor biology and biomarkers, as well as the design of next-generation therapeutics,” Locke said.
This study was funded by Kite, a Gilead Company.
About Moffitt Cancer Center
Moffittis dedicated to one lifesaving mission: to contribute to the prevention and cure of cancer. The Tampa-based facility is one of only 56National Cancer Institute-designated Comprehensive Cancer Centers, a distinction that recognizes Moffitt’s scientific excellence, multidisciplinary research, and robust training and education. Moffitt’s expert nursing staff is recognized by the American Nurses Credentialing Center with Magnet® status, its highest distinction. With more than 9,000 team members, Moffitt has an economic impact in the state of $2.4 billion. For more information, call 1-888-MOFFITT (1-888-663-3488), visit MOFFITT.org, and follow the momentum onFacebook, Twitter,Instagram and YouTube.
###
Locke, F.L., Filosto, S., Chou, J. et al. Impact of tumor microenvironment on efficacy of anti-CD19 CAR T cell therapy or chemotherapy and transplant in large B cell lymphoma. Nat Med (2024). https://doi.org/10.1038/s41591-023-02754-1